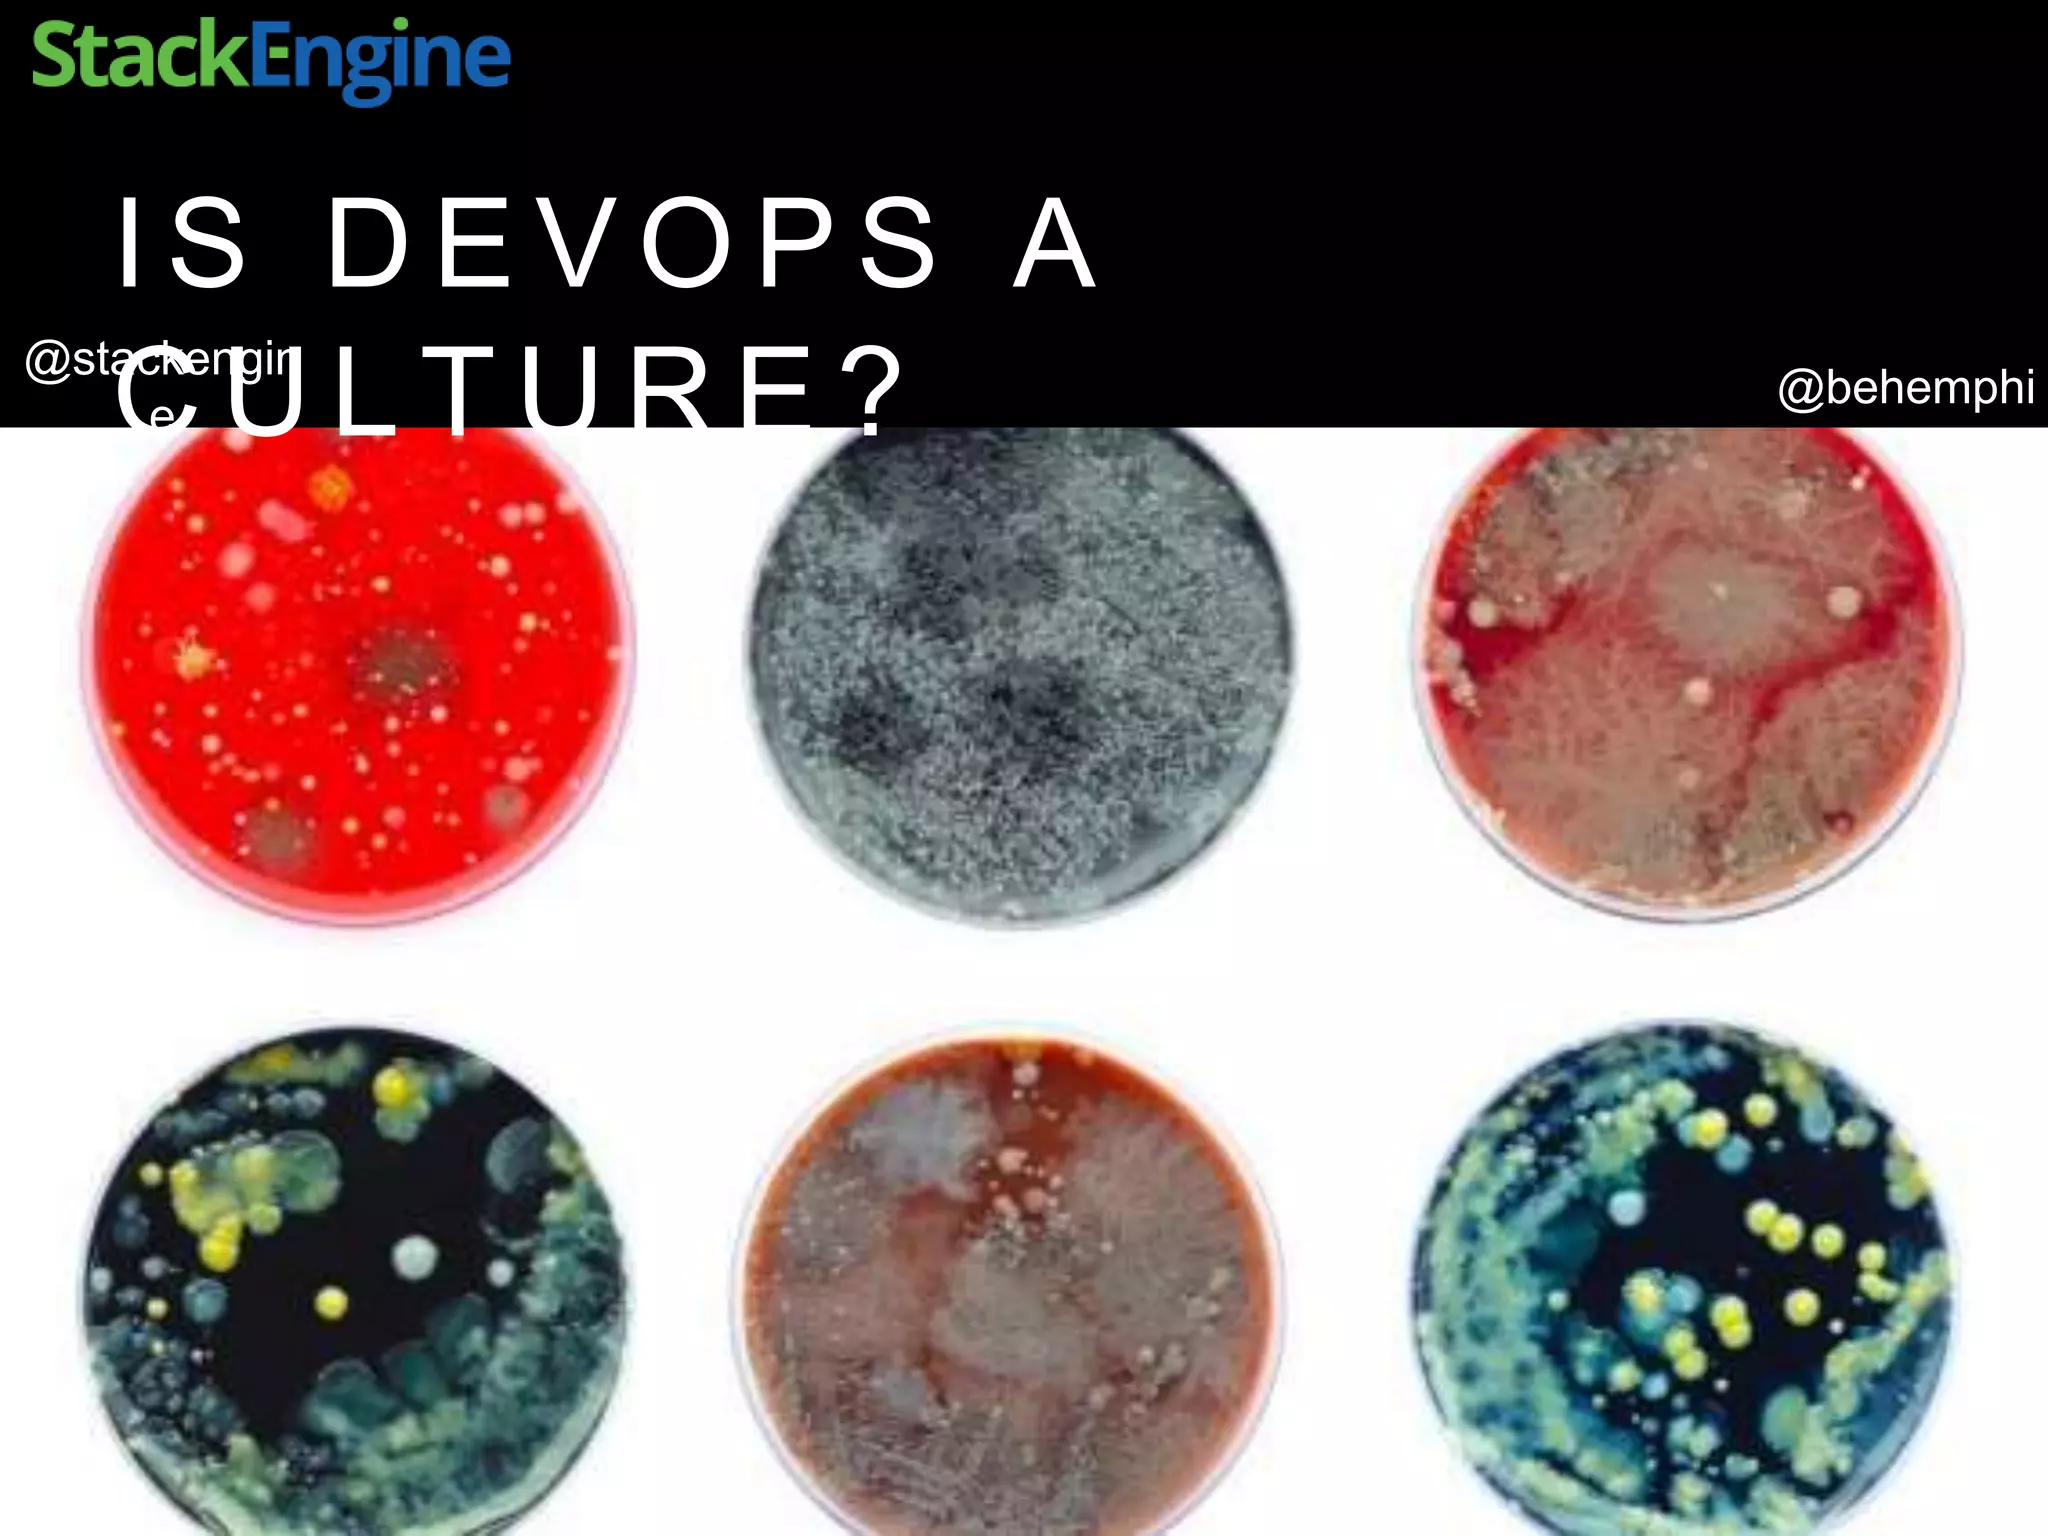
@behemphi
@stackengin
e
I S D E V O P S A
C U L T U R E ?

The document discusses the role of Docker in enabling DevOps practices, highlighting its ease of use in packaging applications within containers. It emphasizes the benefits of microservices architecture, such as increased development velocity and competitive advantage, while detailing the simplification of configuration management. Furthermore, it outlines the efficiency improvements achieved through automation and testing in containerized environments.